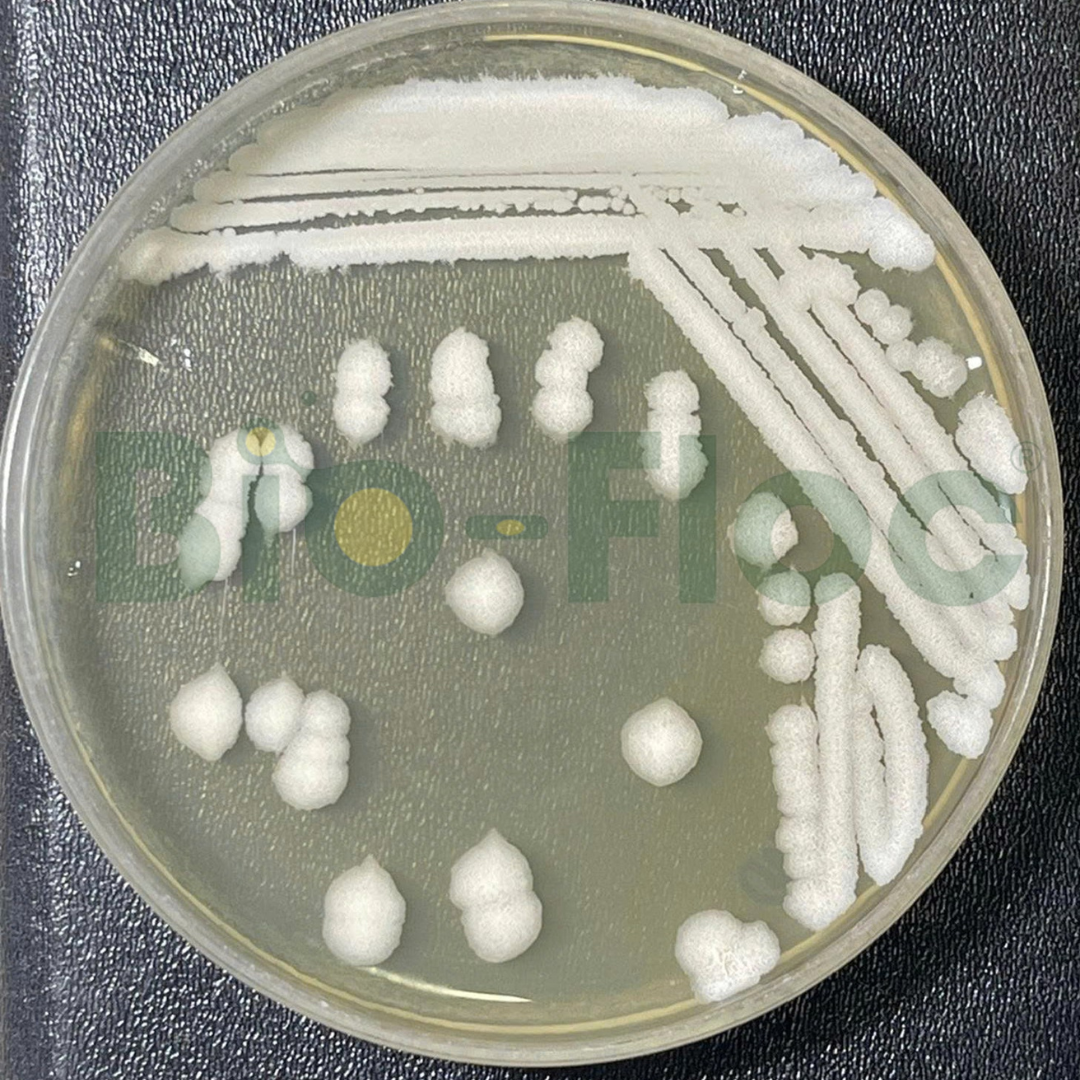
Bacillus amyloliquefaciens
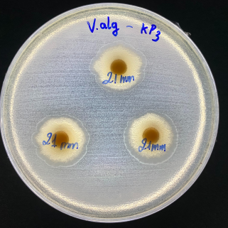
Ba65 của Bio-Floc

Trong lĩnh vực nông nghiệp, các chủng vi khuẩn Bacillus đang ngày càng đóng vai trò quan trọng trong việc thay thế chế phẩm hóa học, cải thiện môi trường và nâng cao hiệu suất nuôi trồng. Trong nhóm này, Bacillus amyloliquefaciens nổi bật nhờ khả năng sinh enzyme mạnh, thích nghi rộng và hiệu quả rõ rệt trong phân hủy hữu cơ, tăng cường tiêu hóa và ức chế mầm bệnh.
Vậy Bacillus amyloliquefaciens là gì, vì sao nó được sử dụng rộng rãi, và giá trị thực tế mà chủng này mang lại?

Contents
1. Tổng quan về Bacillus amyloliquefaciens
Bacillus amyloliquefaciens là vi khuẩn Gram dương, hình que, có khả năng tạo bào tử – yếu tố giúp nó tồn tại bền vững trong điều kiện khắc nghiệt. Đây là chủng vi khuẩn nổi bật với sức mạnh sinh enzyme α-amylase và protease, hai enzyme quan trọng trong phân hủy tinh bột và đạm.
Nhờ khả năng hoạt động ổn định trong nhiều môi trường, loài này được ứng dụng rộng trong:
- Nuôi trồng thủy sản
- Chăn nuôi
- Nông nghiệp hữu cơ
- Xử lý nước và môi trường
- Sản xuất enzyme và men công nghiệp
Sự phân bố
Bacillus amyloliquefaciens được phân lập lần đầu từ đất vào năm 1943 bởi nhà khoa học Nhật Bản Juichiro Fukumoto. Tên gọi xuất phát từ khả năng “làm lỏng tinh bột” của vi khuẩn.
Ngày nay, chủng này được ghi nhận phân bố tự nhiên tại:
- Đất nông nghiệp giàu hữu cơ
- Rễ và mô thực vật
- Nước ngọt – nước lợ – nước mặn
- Thức ăn, nguyên liệu nông nghiệp
Thuộc nhóm Bacillus subtilis complex, loài này có mối quan hệ gần với Bacillus velezensis, Bacillus siamensis…, cho thấy khả năng thích nghi môi trường rất mạnh.
Đặc điểm hình thái
- Vi khuẩn Gram dương, hình que
- Kích thước: 0,7–0,9 × 1,8–3,0 µm
- Tạo bào tử hình bầu dục, không làm phình tế bào
- Thường tồn tại đơn lẻ, không tạo chuỗi dài
- Không di động
Nhờ khả năng tạo bào tử, B. amyloliquefaciens có thể:
- Chịu nhiệt tốt
- Tồn tại trong điều kiện khô hạn
- Kháng tia UV và nhiều tác nhân ức chế
Đây là yếu tố quan trọng giúp vi khuẩn giữ được mật độ cao trong chế phẩm vi sinh.
Đặc điểm sinh hóa
Bacillus amyloliquefaciens có khả năng chuyển hóa đa dạng dưỡng chất:
- Tinh bột, gelatin, casein
- Nhiều loại đường: fructose, glucose, sucrose, cellobiose, maltose, lactose…
Điều kiện sinh trưởng tối ưu:
- Nhiệt độ: 30–40°C
- pH: 7–7,5
- Độ mặn: 0–10%
Đây là dải điều kiện rất phù hợp với môi trường ao nuôi, trang trại chăn nuôi và ứng dụng công nghiệp.
Khả năng sinh enzyme mạnh
Đây là đặc điểm khiến B. amyloliquefaciens được ưa chuộng nhất:
- α-amylase → thủy phân tinh bột
- Protease → phân giải protein
- Ngoài ra còn có khả năng sinh: cellulase, lipase…
Khả năng ức chế vi khuẩn gây bệnh
B. amyloliquefaciens là “đối thủ mạnh” của nhiều vi khuẩn gây bệnh nhờ:
Cơ chế sinh học:
- Sản xuất kháng sinh tự nhiên: macrolactin A, difficidin, bacilysin…
- Cạnh tranh dinh dưỡng và vị trí bám
- Tiết enzyme phân hủy cấu trúc vi khuẩn gây bệnh
- Kích hoạt miễn dịch tự nhiên của vật nuôi
Nhờ đó, vi khuẩn này giúp giảm nguy cơ bệnh như:
- Aeromonas spp.
- Vibrio spp.
- Streptococcus spp.
và nhiều mầm bệnh cơ hội khác.
2. Ứng dụng thực tế nổi bật của Bacillus amyloliquefaciens trong nông nghiệp
Trong nuôi trồng thủy sản
- Phân giải nhanh bùn đáy – thức ăn dư
- Giảm NH₃, NO₂, H₂S
- Cải thiện tiêu hóa, tăng sức khỏe đường ruột
- Ổn định hệ vi sinh nước
Trong nông nghiệp
- Tăng sinh trưởng rễ, kích thích tiết chất điều hòa sinh trưởng
- Ức chế nấm bệnh như Fusarium, Rhizoctonia
- Cải thiện đất bạc màu
Trong công nghiệp – môi trường
- Sản xuất enzyme tinh bột và protein
- Ứng dụng trong xử lý nước, xử lý chất thải
3. Ưu thế của Bio-Floc: Chủng Bacillus amyloliquefaciens tuyển chọn – thuần – mạnh – ổn định

Tại Bio-Floc, Bacillus amyloliquefaciens Ba65 được tuyển chọn từ các vùng sinh thái bản địa, trải qua quá trình lưu giữ – kiểm nghiệm – chuẩn hóa nghiêm ngặt.
Chủng mã hóa Ba65 của Bio-Floc sở hữu các ưu điểm vượt trội:
- Thuần chủng – mật số cao – hoạt tính enzyme mạnh
- Ổn định trong môi trường mặn, lợ, ngọt
- Phân giải tinh bột, đạm và hữu cơ vượt trội
- Tương thích cao với hệ vi sinh bản địa Việt Nam
- Hoạt động tốt trong nhiều công thức chế phẩm:
- xử lý nước
- xử lý đáy
- men tiêu hóa, probiotic
Với thế mạnh chủng bản địa – công nghệ lên men chuẩn hóa – kiểm soát chất lượng nghiêm ngặt, Bio-Floc mang đến nguồn nguyên liệu vi sinh ổn định, hiệu quả và chuyên biệt, giúp các nhà máy và doanh nghiệp tạo ra sản phẩm có tính cạnh tranh cao, phù hợp thị trường và mang lại giá trị lâu dài.
Tìm hiểu về nguyên liệu vi sinh Bacillus amyloliquefaciens Ba65

